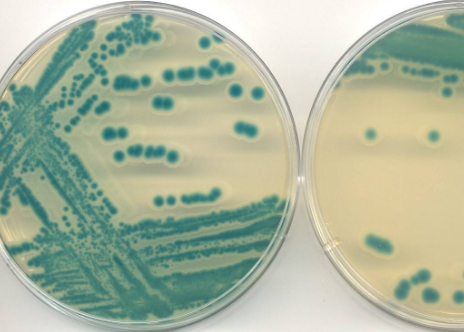
斜面培养基.png

动态资讯
掌握全球贸易最新动向洞见行业未来
斜面培养基(agarslantculture-medium ):固体培养基(solid culture medium )的一种形式;制作时应趁热定量分装于试管内,并凝固成斜面的称为斜面培养基,用于菌种扩大转管及菌种保藏。
一、半固体培养基进口报关手续资料
1、收发货人备案号;
2、原标签和对应中文翻译件;
3、进出口经营权;
4、官方原产地证书;
5、生产国官方卫生证书/自由销售证明;
6、生产商成分检测报告/灌装证明;
7、装箱单、发票及合同等;
8、产品信息:品名、数量、包装、重量及体积等;
二、半固体培养基进口报关流程;
1、到港;
2、支付运费、船代处换单;
3、报检、报关及申报价格;
4、海关审价出税单;
5、缴纳税金;
6、海关查柜;
7、放行货物;
8、提货;
9、送货至国内指定地点;
本文标签:
400电话:400-1598-021
qq:3001398809
地址:东莞市南城区宏北路18号碧
桂园中心2206-2207